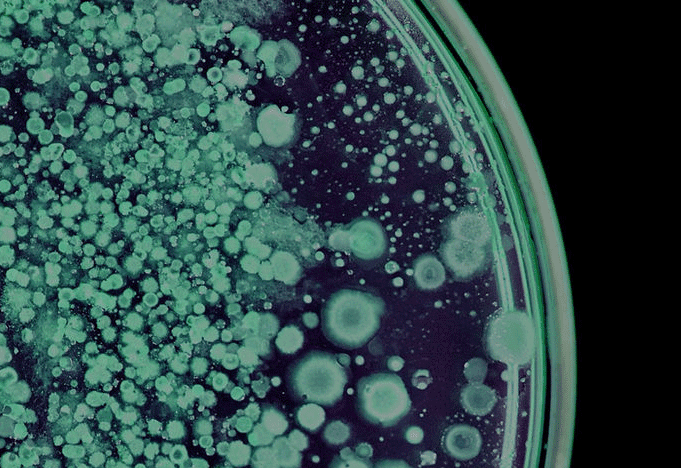
Pluton Bio

Venture

Pluton Bio
Biotech
Pluton Bio uses advanced microbial discovery to develop novel biologicals for agriculture, improving soil health and crop performance.

Pluton Bio uses advanced microbial discovery to develop novel biologicals for agriculture, improving soil health and crop performance.